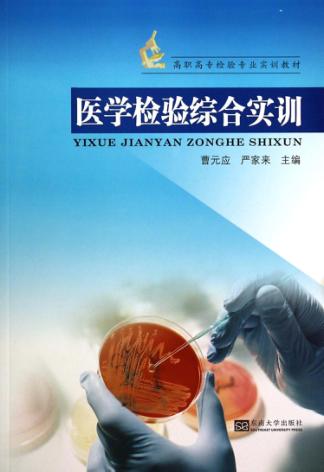
医学检验综合实训 封面

医学检验综合实训
作者: 曹元应,严家来主编
关键词: 医学检验-高等职业教育-教材-医学检验
页数:142
出版社: 南京:东南大学出版社
出版日期:
发现《医学检验综合实训》在 2023-03-14 可全文阅读或下载。
图书简介
医学检验综合实训
用户须知
出版社通过教客网下载电子书并起诉站长多次,本站随时可能倒闭。
诉讼案号:(2022)川01民初4401,(2022)川01民初4403,(2022)川01民初4403,(2022)川0191民初19351号, (2022)川0191民初19594号,(2022)川0191民初20457号,(2022)川0191民初20459号, (2023)川知民终373号,(2023)川知民终374号,(2023)川知民终375号, (2024)川0191民初15977号,(2024)川0191民初15979号,(2024)川0191民初15980号, (2024)川0191民初15981号,(2024)川0191民初15982号
- 如果要找《医学检验综合实训》,可以尝试去图书馆。
- 本页面文字内容和图片来自 m.5read.com。
- 封皮图片引用地址:https://unicover.duxiu.com/coverNew/CoverNew.dll?iid=716E67686E7167706C6C5EABABA4A19AAA99AAB15E693433323937363738
